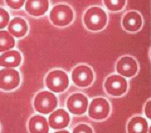
���ڃ}�b�T�[�W�{�p��̐Ԍ���

東京を中心に埼玉、神奈川近郊への【出張専門足つぼマッサージ療法院】です。
お電話でのご予約・お問い合わせはTEL.03-6403-5963
営業時間:10:00~19:00
>>予約フォーム<<
〒108-0074 東京都港区高輪4-23-6
足つぼマッサージ臨床研究Clinical
診足つぼマッサージ研究について
街中、至る所に足つぼの店がありますが、足つぼをすると「ダイエット・便秘などに効く」と宣伝されています。
お客様からも、「膝の痛みがなくなりました」、「頭痛が起きる間隔が長くなりました」、「健康診断での数値が改善されました」などと言われます。
具体的に何故よくなったのか私自身も気になります。
そしてもし本当に改善されるのであれば医学的な検査で大まかには分かるのではないかと言うことから私の足つぼ研究が始まりました。
お客様の医療機関でのデータの変化、体の変化、感想などいただいたものを集め、
自身の成長やお客様のために日々研究をしています。自然治癒力を最大限発揮する事が願いですから。
施術前・施術後で体にどのような変化があるのかを知りたいだけであり,それはお客様の方からのご要望でもあります。
ご協力いただいたお客様には大変感謝しております。
※個人差がございます。
足つぼマッサージの即効性(サーモグラフィ)
足つぼマッサージとサーモグラフィ
中国医学では病気になる要因の一つとして血液の流れ、二つ目は気の流れと言われています。気の流れは一般の方には理解しづらいところがあり、分かりやすいのは血の流れです。最近、体温が1℃下がると、免疫力が30%低下するということが言われています。体を温めるのが血液です。
サーモグラフィを使って体温や血液の流れを観察します。
足ツボは「痛いほうが効果がある」、という施術者もいれば「痛くなくても効果がある」と主張している施術者もいます。そこでサーモグラフィを使い体温の変化を調べてみました。
同じ流派(足つぼの)の施術者の方に依頼(①卒業二年弱の施術者・②経験豊富な施術者)し、
同じ施術時間で実施しました。
結果は下のサーモグラフィの画像となります。
①番は一生懸命施術をしましたが、(施術は左足から始め次に右足を施術するのですが)右足の施術終了後に左の足の温度が元に戻ってしまいました。施術を受けた方の話によると、痛みはありますが表面だけの痛さなのか、奥までジンとこない印象だとおっしゃっていました。
①番施術前(足裏) |
①番施術前(足甲) |
①番施術後(足裏) |
①番施術後(足甲) |
②番は①番とは逆でした。右足が終了後でも左の足の温度は高いままでした。(下記写真:施術後参照)時間が経過しても左足の温度は施術後とさほど変わらないということです。
施術を受けた方の話によると奥まで伝わってくるような痛みが印象のようでした。
ここで分かったことは個人差はありますが、同じ足つぼ流派でも経験ある施術者とない経験者では差があります。
痛い施術でもその施術者によって効果が変わります。サーモグラフィを通じて足つぼの即効性を出す為にはある程度の痛みが必要だと判明しました。
②番施術前(足裏) |
②番施術前(足甲) |
②番施術後(足裏) |
②番施術後(足甲) |
※足つぼ流派:大まかに東洋式(痛みがあります)・西洋式です(東洋式に比べ痛みは少ない)。
両方ともリフレクソロジーと言います。現在東洋式は台湾式が主流・西洋式は英国式が主流。
足つぼマッサージの即効性(血液検査)
足つぼマッサージと血液検査比べ
私達はお客様そして病院のご協力を得て、施術前と施術後の血液の変化を観察しました。
40分間の施術後の体の変化とはどのようなものでしょう。
結果は以下となります。コレステロール、中性脂肪などが全員下がりました。
ということは足つぼマッサージによって、コレステロール、中性脂肪などが下がりやすいと考えられます。(コレステロールや中性脂肪が基準値を上回る状態が続くと動脈硬化が促進され、進行すると脳卒中や狭心症、心筋梗塞などを引き起こす危険因子となります。)
 |
 |
足つぼマッサージの臨床研究(ガンの緩和ケア)
足つぼマッサージによるガンの緩和ケア
私達は足つぼマッサージによる癌の緩和ケアを実施しております。
これまでに施術させていただいたものは、乳癌・肺癌・大腸癌・肝臓癌・粘膜癌・胃癌・節癌・脳腫瘍です。
足つぼマッサージによってガンの痛み緩和する
医学では、癌の痛みを緩和する方法として、非オピオイド鎮痛薬・弱オピオイド鎮痛薬・強オピオイド鎮痛薬を使用しています。しかし、このような薬を常に服用すると肝障害・腎障害・穿孔・心不全などを引き起こしやすくなるといわれています。
そこで、足つぼマッサージ・針などで痛みを和らげ、できるだけ薬を減らし、その副作用を防ぐことが重要です。
足つぼマッサージをすることにより、薬のいい成分を吸収し、悪い成分を体外に排出することができるのです。
「不通則痛」=通りが悪くなって起こる痛み
「通則不痛」=通りがよくなれば痛みもなくなる
血液の流れが圧迫されることにより、流れが悪くなり、痛みが起こります。足つぼマッサージをすることによって血液の流れがよくなり、痛みを緩和することができるのです。
| 赤外線写真です。 足つぼマッサージ終了後、血液が完全に足に回ったことがわかります。 |
|
 |
施術前 |
施術中 |
|
施術後 |
|
足つぼマッサージの臨床研究 免疫力の変化
足つぼマッサージによる免疫力が上がりました
第三癌の治療法は放射線・化学療法・手術。このような治療法は悪い細胞もいい細胞も殺してしまうため、体にかなり負担をかけてしまいます。足つぼマッサージをすることによって、体にとっていい細胞を保護しながら、このような治療法を続けることができます。
≪粘膜癌・肝臓癌・大腸癌の患者さんの経験≫
免疫治療・抗がん剤治療途中で、自己免疫力が下がってしまいました(血液検査で白血球などが下がり過ぎとなる)。
自己免疫力が下がり過ぎると他の病気にかかったろ、癌が転移する場合がありますので、治療を一時停止することになります。
しかし、この患者さんたちは足つぼマッサージを受けたこともあり、自己免疫力が徐々に上昇し、そのことが血液検査の結果でも分かったため、医療的な治療も続けることができました。
足つぼマッサージ受ける前の赤血球 |
足つぼマッサージ受けた後の赤血球 |
足つぼマッサージ受ける前の血液検査 |
|
足つぼマッサージ受けて6ヶ月後の血液検査 |
|
足つぼマッサージによるガンの周辺症状の緩和
だるい・眠れない・むくみ・食欲がないなどの症状を緩和
このような症状で常に悩んでいると、精神的に疲れてしまします。そうなると癌の病状悪化や再発などに繋がります。
私達の経験ですが、不眠の方でも足つぼマッサージをしている最中は体がリラックスし、寝ている方が多くいらっしゃいます。また、足つぼマッサージした後に体のだるさがなくなるという方も多いのです。
薬・精神的などの原因で胃腸の動きが鈍くなってしまい、食欲がない方も足つぼマッサージによって胃腸の動きが活発することができると関西大学医学部では証明されています。
多発神経障害は、末梢神経の機能不全による脱力、感覚麻痺、反射の低下などを引き起こします。また、歩行が不安定になる、腕や脚の協調運動ができない、発語障害、めまい、複視があるといった症状が現れることがあります。
足つぼマッサージは末端である足を刺激し、そのような症状改善することや防ぐことができます。症状の改善は足つぼマッサージの得意分野なのです。
なぜ、このようなことできるかというと足裏は人縮影(足裏には、人間の体が投影されている)からなのです。
 |
 |
足つぼマッサージによる不正出血防止
癌は血管を圧迫して体の血の流れを悪くし、十分な新陳代謝ができなくなります。
新陳代謝が悪くなると体の新しい細胞も生まれにくくなります。それによって出血を防ぐ役目している血小板の数も減ります。癌により出血が起きる場合に抑えることができなくなって、危険な状態になってしまいます。
足つぼマッサージすることによって、血液の流れがよくなることで、血小板の数値があげることができます。
そうなると癌による出血のリスクを防ぐことに繋がります。
出張専門 一楽足つぼ療法院

〒108-0074
東京都港区高輪4-23-6
TEL.03-6403-5963
>>予約&料金<<
>>予約フォーム<<


ご予約方法出張専門足ツボマッサージ専門療法院
>>予約フォーム<<
?TEL 03-6403-5963
?TEL 080-1317-7878
?FAX 03-6893-3931
?営業時間 10:00~19:00
お客様の声出張専門足ツボマッサージ専門療法院

お客様の声出張専門足ツボマッサージ専門療法院

一般社団法人
メディカルリフレクソロジー足つぼマッサージ出張専門療法院
〒108-0074
東京都港区高輪4-23-6
TEL 03-6403-5963
FAX 03-6893-3931
